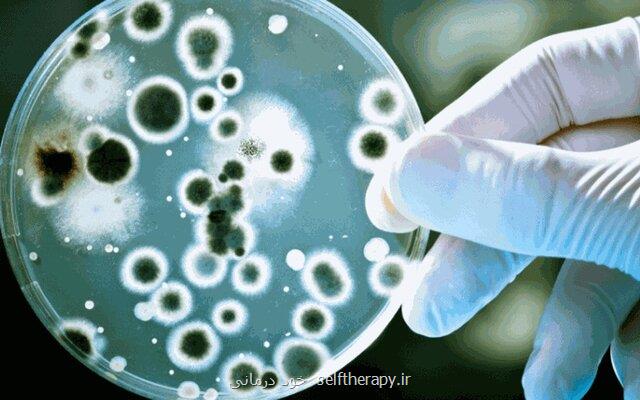
چطور به دست خودمان موثرترین داروی دنیا را نابود کردیم؟

چطور به دست خودمان موثرترین داروی دنیا را نابود کردیم؟
به گزارش خود درمانی بر اثر ۸۰ سال استفاده نادرست از پنی سیلین، حالا افزایش سطح «مقاومت آنتی بیوتیکی» به مرز اخطار رسیده است.
به گزارش خود درمانی به نقل از ایسنا، تا دو سال پیش شاید تصوری از شادی مردم پس از دستیابی به داروی معجزه آسایی مانند پنی سیلین را نداشتیم، اما یک سال و نیم پس از تقلای هر روزه برای یافتن داروی بیماری کووید-۱۹، می توانیم تصور نماییم مردم کره زمین پس از آنکه در دو جنگ جهانی ویرانگر و مرگ میلیونها نفر بر اثر عفونت ناشی از جراحت های جنگی، داروی آنتی بیوتیک و تزریقی پنی سیلین را در دست گرفتند چه احساسی داشتند.
پنی سیلین، میراث الکساندر فلمینگ اسکاتلندی برای بشریت است. او که این روزها سالروز تولد ۱۴۰ سالگی اش در گوشه و کنار دنیا جشن گرفته می شود، سال ها به دنبال دارویی بود که عفونت را بدون صدمه زدن به بافت سالم بدن، کنترل کند.
شاید داستان کشف پنی سیلین را به صورت داستان جذابِ رویشِ تصادفی کپک روی نمونه آزمایش شنیده باشید اما حقیقت این است که فلمینگ نزدیک به ۲۰ سال از عمر خویش را صرف به ثمر رسیدن این دارو کرد.
تولید «داروی معجزه گر» در ابتدا بسیار محدود بود و تنها، راهیِ جبهه های نبرد در اروپا می شد اما بعد از آخر جنگ جهانی دوم، کم کم در دسترس عموم قرار گرفت و عمل جراحی را از یک قمار خطرناک تبدیل به راه شفا و بهبودی کرد.
در سال ۱۹۴۵ میلادی فلمینگ و دو محقق انگلیسی دیگر به نامهای هاوارد فلری و ارنست چاین، جایزه نوبل در پزشکی را به خاطر این کشف بزرگ گرفتند.
به نوشته روزنامه ایندیپندنت، متأسفانه استفاده نادرست و فراگیر از این دارو در ۸۰ سال قبل سبب شده است که پزشکان اعلام کنند، افزایش سطح «مقاومت آنتی بیوتیکی» الان به مرز اخطار رسیده است.
طبق تعریف سازمان جهانی بهداشت، مقاومت به آنتی بیوتیک یعنی میکروب های بیماری زا که برای از بین بردن آنها از آنتی بیوتیک استفاده می شود، با جهش ژنی (موتاسیون) نسبت به این داروها مقاوم شوند.
مصرف خودسرانه آنتی بیوتیک یکی از علل ایجاد این بحران است. هم اکنون در خیلی از کشورها قوانین محدود شونده ای برای تجویز و استفاده از این نوع داروها وضع شده است. پزشکان و مقامات بهداشتی جهانی امیدوارند با وضع این محدودیت ها بتوانند میزان اثرگذاری این داروی نجات بخش را حفظ نموده و میراث فلمینگ را دست کم برای یک قرن دیگر زنده نگه دارند.
این مطلب را می پسندید؟
(1)
(0)
تازه ترین مطالب مرتبط
نظرات بینندگان در مورد این مطلب